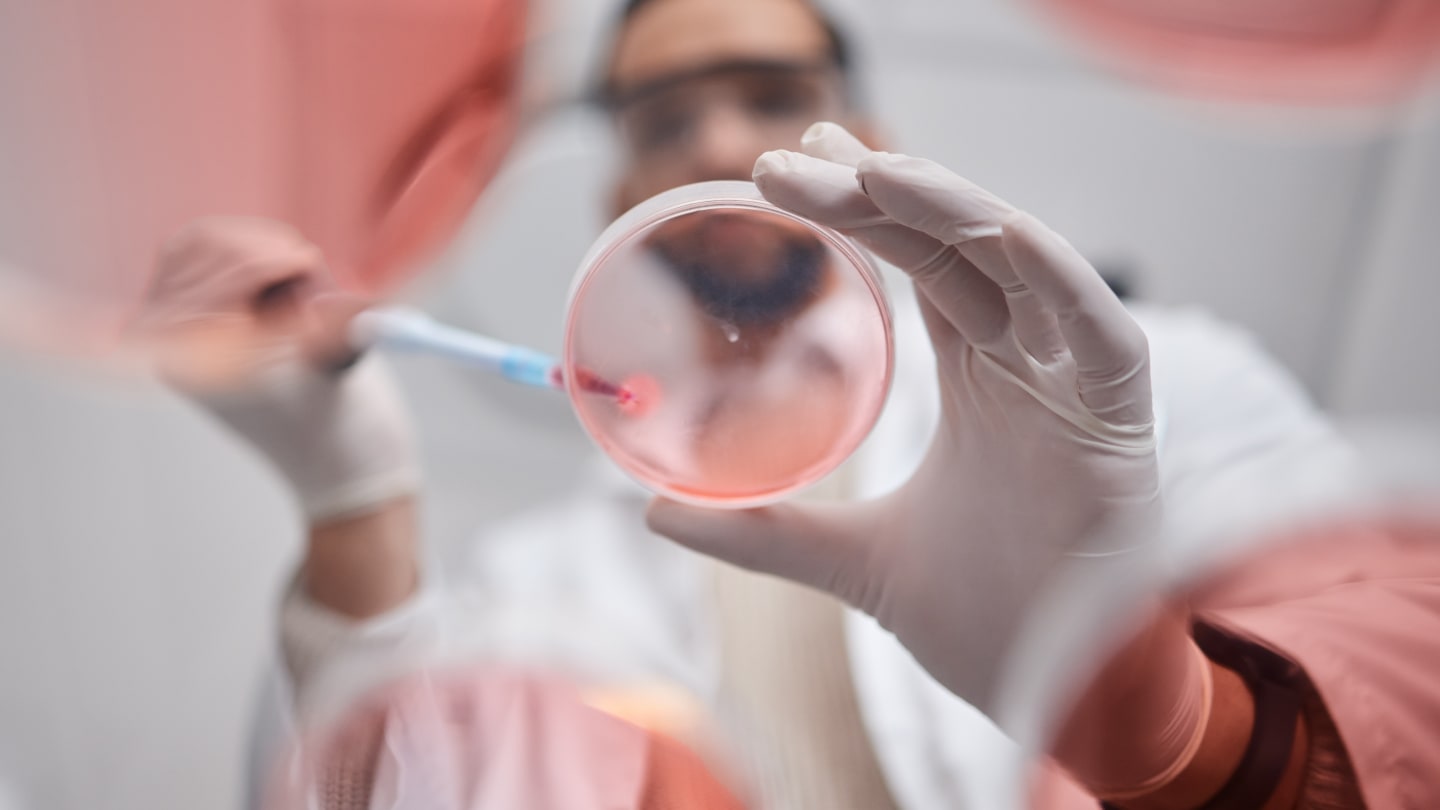

Improved kidney transplant survival rate with imlifidase
Hansa Biopharma has presented five-year follow-up data from the 17-HMedIdeS-14 study at the 2025 ESOT Congress in London, highlighting the long-term efficacy of imlifidase (Idefirix) in kidney transplantation for highly sensitized patients. The study reported a 90 percent patient survival rate and 82 percent graft survival rate over five years, with a mean estimated glomerular filtration rate (eGFR) of 50 mL/min/m², indicating sustained kidney function. These outcomes align with three-year post-transplant results, suggesting durable benefits. The findings support imlifidase as a viable desensitization therapy, enabling successful HLA-incompatible kidney transplants and offering a transformative alternative to prolonged dialysis dependency.
ARTAN Bio and Syenex age suppression partnership
Artan Bio has partnered with Syenex to utilize its VivoCell platform for the precise in vivo delivery of next-generation codon suppressors targeting aging-related diseases. The collaboration aims to enhance the delivery of codon suppressors, which can modulate gene expression by overriding premature stop codons, thereby restoring the production of full-length proteins. By combining Artan Bio's expertise in codon suppression with Syenex's advanced delivery system, the partnership seeks to develop innovative therapies that address the molecular mechanisms of aging, potentially offering new treatments for age-associated conditions.
FDA approves Gamifant
The US FDA has approved Sobi’s Gamifant (emapalumab-lzsg) as the first-ever treatment for macrophage activation syndrome (MAS) in patients with Still’s disease, including systemic juvenile idiopathic arthritis (sJIA) and adult-onset Still’s disease (AOSD). This approval is based on pooled data from two pivotal studies, EMERALD and NI-0501-06, where 54 percent of patients achieved complete response at week eight, and 82 percent reached clinical MAS remission. Gamifant, an anti-interferon gamma monoclonal antibody, offers a targeted approach to controlling hyperinflammation in MAS, a life-threatening complication of rheumatic diseases. The treatment also demonstrated a significant reduction in glucocorticoid use, addressing a critical unmet need in this patient population.
AI for Antibodies
Chai Discovery has introduced an AI model that could advance antibody design. Previous iterations tended to offer hit rates below 0.1 percent, Chai-2 achieves nearly a 20 percent success rate by designing all complementarity-determining regions (CDRs) from scratch using only target and epitope information. In laboratory tests across approximately 50 antibody targets, nearly half yielded validated hits with fewer than 20 designs per target. These antibodies demonstrated nanomolar-range affinities, high specificity, and strong developability profiles. Notably, Chai-2 produced validated binders for all five tested miniprotein targets, outperforming previous methods. The platform aims to accelerate in silico generation to lab validation.




